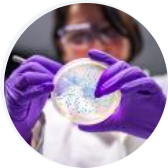

Charla de presos y personal de Villabona
Charla de presos y personal de Villabona
El pasado martes 20-1-26 tuvo lugar en nuestro instituto una charla propuesta por la comisión de convivencia del Consejo Escolar en la que participaron varios presos de Villabona y personal del...
 Salida ruta río Peñafrancia 1º Y 3º ESO
Salida ruta río Peñafrancia 1º Y 3º ESO
En dos jornadas de octubre, el alumnado de 1º y 3º ESO del IES Calderón de la Barca participó en una ruta por la senda del río Peñafrancia; fue una jornada de convivencia y confraternización en la...
 Visita a la EPI del alumnado de Física
Visita a la EPI del alumnado de Física
El alumnado de 2º Bachillerato que cursa la materia de Física ha acudido en compañía de sus profesoras, Beatriz y Noelia a la Escuela Politécnica de Gijón para realizar una actividad...
 Intercambio con Alemania
Intercambio con Alemania
Alumnos de 3º ESO y de 1º de Bachillerato de nuestro instituto han participado en un intercambio escolar con el instituto Albert Schweitzer de Offenbach am Main. Todos han disfrutado enormemente...
 Visita al Parque de la Vida
Visita al Parque de la Vida
Los alumnos y alumnas de B1E y B1C de biología, geología y ciencias ambientales, más los de Anatomía aplicada que no cursan la asignatura anterior, de B1A, B1B y B1C, realizaron una actividad...
 11 de febrero: Día Internacional de la Mujer y la Niña en la Ciencia
11 de febrero: Día Internacional de la Mujer y la Niña en la Ciencia

 Visita al CIFP del Mar
Visita al CIFP del Mar

 Visita al CIFP de la Laboral
Visita al CIFP de la Laboral

 Visita al Banco de España y Europa Direct por alumnado de 1º de Bachillerato y 4º ESO Diver
Visita al Banco de España y Europa Direct por alumnado de 1º de Bachillerato y 4º ESO Diver

 Visita al observatorio de Deva
Visita al observatorio de Deva